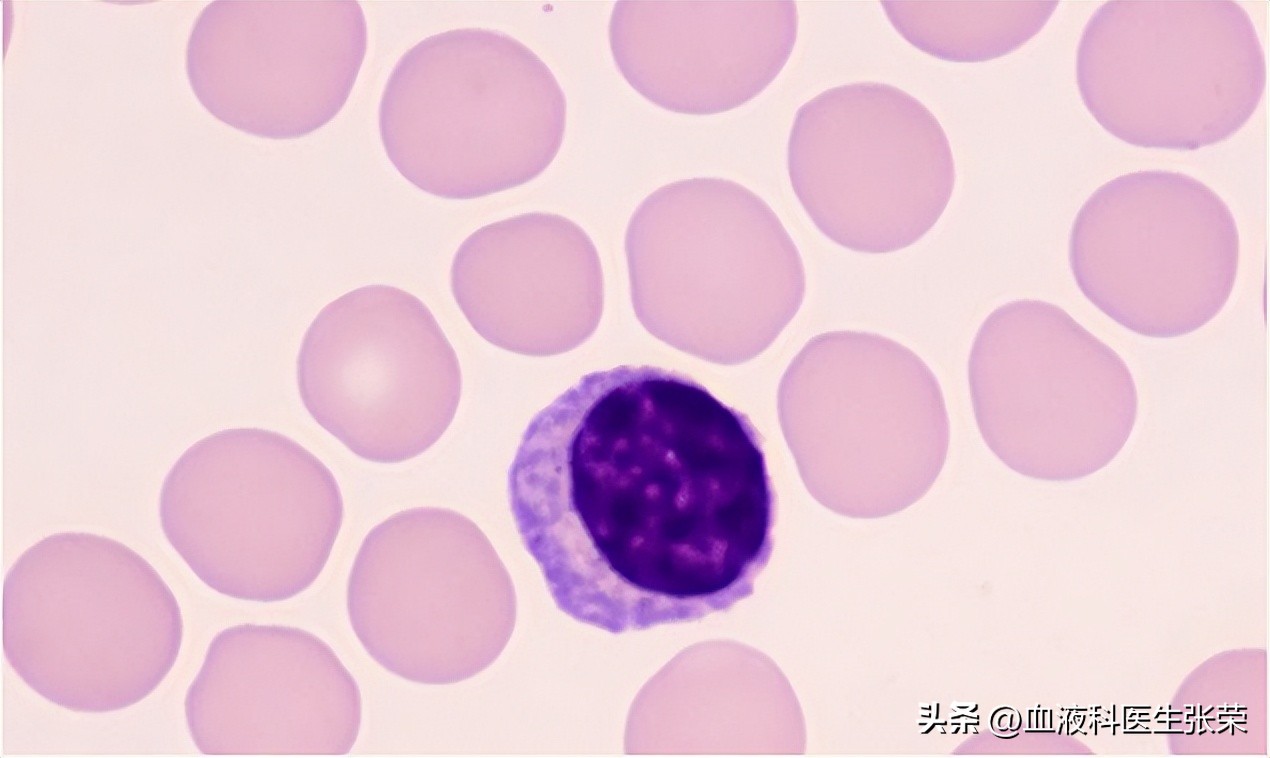
免疫功能紊乱血小板低,血小板减少凝血功能差如何调理

免疫性血小板减少症属于一类获得性自身免疫性疾病,目前公认绝大多数ITP是由于免疫介导的自身抗体致敏的血小板被单核巨噬细胞系统过度破坏所致。也有新的观点认为是免疫介导损伤巨核细胞或抑制巨核细胞释放血小板,造成患者血小板生成不足。

血小板减少免疫功能紊乱,如何调理?
现在西医临床上治疗血小板减少症主要治疗方案有降低免疫反应的激素治疗、减少血小板被破坏的脾切除手术、增加机体免疫力、调节免疫的丙种球蛋白治疗等。
由此可见,其中对免疫系统有局部针对性的是丙种球蛋白治疗方案,那丙种球蛋白能促进免疫系统恢复正常吗?
其实,免疫球蛋白对免疫系统虽然有调节作用,但血小板减少症病程较长,如果长期输注丙球蛋白,可能会出现耐药性,还可能抑制人体免疫屏障。因此丙球冲击多用于应急措施。
患者要想促进免疫系统恢复正常,除了可以西医治疗,还可以适当的使用中药治疗,中药调理过程虽然相对西医来说较慢,但起效可减少病情反复。现在越来越多的免疫性血小板减少症患者选择使用中西医结合治疗。

不过平时一些不良的生活习惯,也会破坏免疫功能,包括长期睡眠不足、情绪压抑、不注意卫生等等,一旦人体免疫功能紊乱,就容易诱发疾病,所以养成良好的生活习惯,对于免疫性血小板减少症患者来说也同样重要。